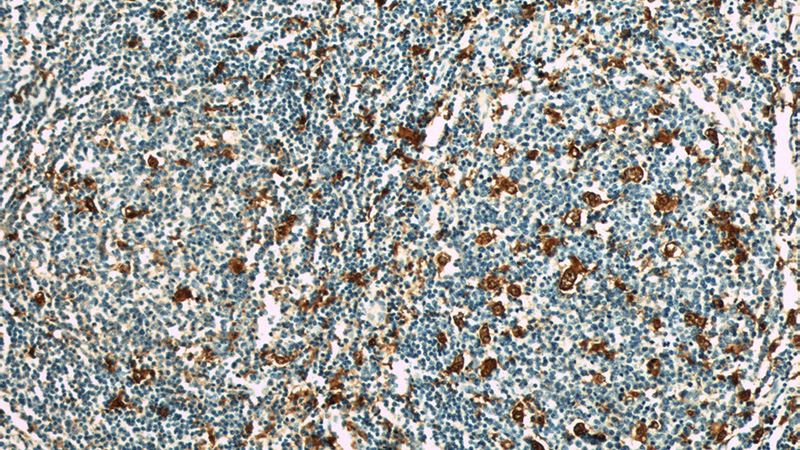
Immunohistochemical of paraffin-embedded human tonsillitis using Catalog No:114182(Pre-IL18 antibody) at dilution of 1:50 (under 10x lens)

-
Product Name
Pre-IL18 antibody
- Documents
-
Description
Pre-IL18 Rabbit Polyclonal antibody. Positive IP detected in HeLa cells. Positive WB detected in HeLa cells, Transfected HEK-293 cells. Positive IHC detected in human tonsillitis tissue, human colon cancer tissue. Positive IF detected in HeLa cells. Observed molecular weight by Western-blot: 18-24 kDa
-
Tested applications
ELISA, WB, IP, IHC, IF
-
Species reactivity
Human; other species not tested.
-
Alternative names
IbOCtadekin antibody; IFN gamma inducing factor antibody; IGIF antibody; IL 1 gamma antibody; IL 18 antibody; IL 1g antibody; IL18 antibody; IL1F4 antibody; Interleukin 1 gamma antibody; Interleukin 18 antibody; Mature IL18 antibody; pre IL18 antibody
-
Isotype
Rabbit IgG
-
Preparation
This antibody was obtained by immunization of Pre-IL18 recombinant protein (Accession Number: NM_001386420). Purification method: Antigen affinity purified.
-
Clonality
Polyclonal
-
Formulation
PBS with 0.1% sodium azide and 50% glycerol pH 7.3.
-
Storage instructions
Store at -20℃. DO NOT ALIQUOT
-
Applications
Recommended Dilution:
WB: 1:500-1:5000
IP: 1:500-1:5000
IHC: 1:20-1:200
IF: 1:10-1:100
-
Validations

HeLa cells were subjected to SDS PAGE followed by western blot with Catalog No:114182(Pre-IL18 antibody) at dilution of 1:1000

IP Result of anti-Pre-IL18 (IP:Catalog No:114182, 3ug; Detection:Catalog No:114182 1:1000) with HeLa cells lysate 5000ug.
Immunohistochemical of paraffin-embedded human tonsillitis using Catalog No:114182(Pre-IL18 antibody) at dilution of 1:50 (under 10x lens)

Immunohistochemical of paraffin-embedded human tonsillitis using Catalog No:114182(Pre-IL18 antibody) at dilution of 1:50 (under 40x lens)

Transfected HEK-293 cells were subjected to SDS PAGE followed by western blot with Catalog No:114182(Pre-IL18 Antibody) at dilution of 1:1000

Immunofluorescent analysis of HeLa cells using Catalog No:114182(Pre-IL18 Antibody) at dilution of 1:25 and Alexa Fluor 488-congugated AffiniPure Goat Anti-Rabbit IgG(H+L)
-
Background
IL18, is a proinflammatory cytokine involved in the development of Th1 cells and in immune response. It can stimulate the NK cells and certain T cells to release interferon gamma which plays an important role in activating the macrophages or other cells. IL18 has been demonstrated to have the potential to enhance Fas ligand-mediated cytotoxicity, which is increased in PE and regulates placental apoptosis. IL18 is synthesized as a 24 kDa precursor and then cleaved into a biologically activate 18 kDa form. This antibody 10663-1-AP is raised against the full length IL18 precursor, and it recognizes both the pre-IL18 and mature IL18 theoretically.
-
References
- Tian Z, Wang XY, Zhou YF. Schistosoma japonicum scFv-IL18 fusion DNA ameliorates hepatic fibrosis in schistosomiasis-infected mice via improving local concentration of IL-18 in liver. Experimental parasitology. 134(4):447-54. 2013.
- Altaf A, Qu P, Zhao Y, Wang H, Lou D, Niu N. NLRP3 inflammasome in peripheral blood monocytes of acute coronary syndrome patients and its relationship with statins. Coronary artery disease. 26(5):409-21. 2015.
Related Products / Services
Please note: All products are "FOR RESEARCH USE ONLY AND ARE NOT INTENDED FOR DIAGNOSTIC OR THERAPEUTIC USE"
